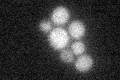
YNL016W
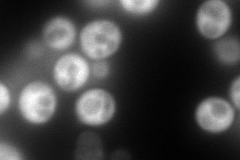
YNL016W
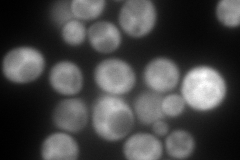
YNL016W
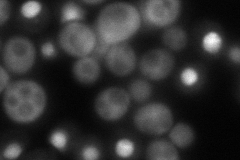
YNL016W
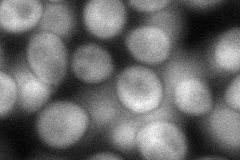
YNL016W
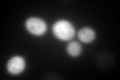
YNL016W
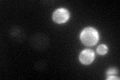
YNL016W

View description
Poly (A)+ RNA-binding protein, abundant mRNP-component protein that binds mRNA and is required for stability of many mRNAs; component of glucose deprivation induced stress granules, involved in P-body-dependent granule assembly
Localization:
Intensity:
Fold change:
Significance:
-
C’ GFP library in SD
below threshold17.78 -
N' NOP1pr-GFP in SD
cytosol334.278 -
N' TEF2pr-mCherry in SD
cytosol413.124 -
N' NATIVEpr-GFP in SD
nucleus129.885 -
N' TEF2pr-VC and Cyto-VN in SD
cytosol82.7766 -
C’ GFP library in SD+DTT
cytosol18.991.06No -
C’ GFP library in SD+H2O2

cytosol23.821.33No -
C’ GFP library in Starvation Media
cytosol17.811No -
C’ GFP library on the background of Pup2-DaMP

below threshold -
C’ GFP library on the background of CCT mutant

below threshold227.16312.7703Yes
